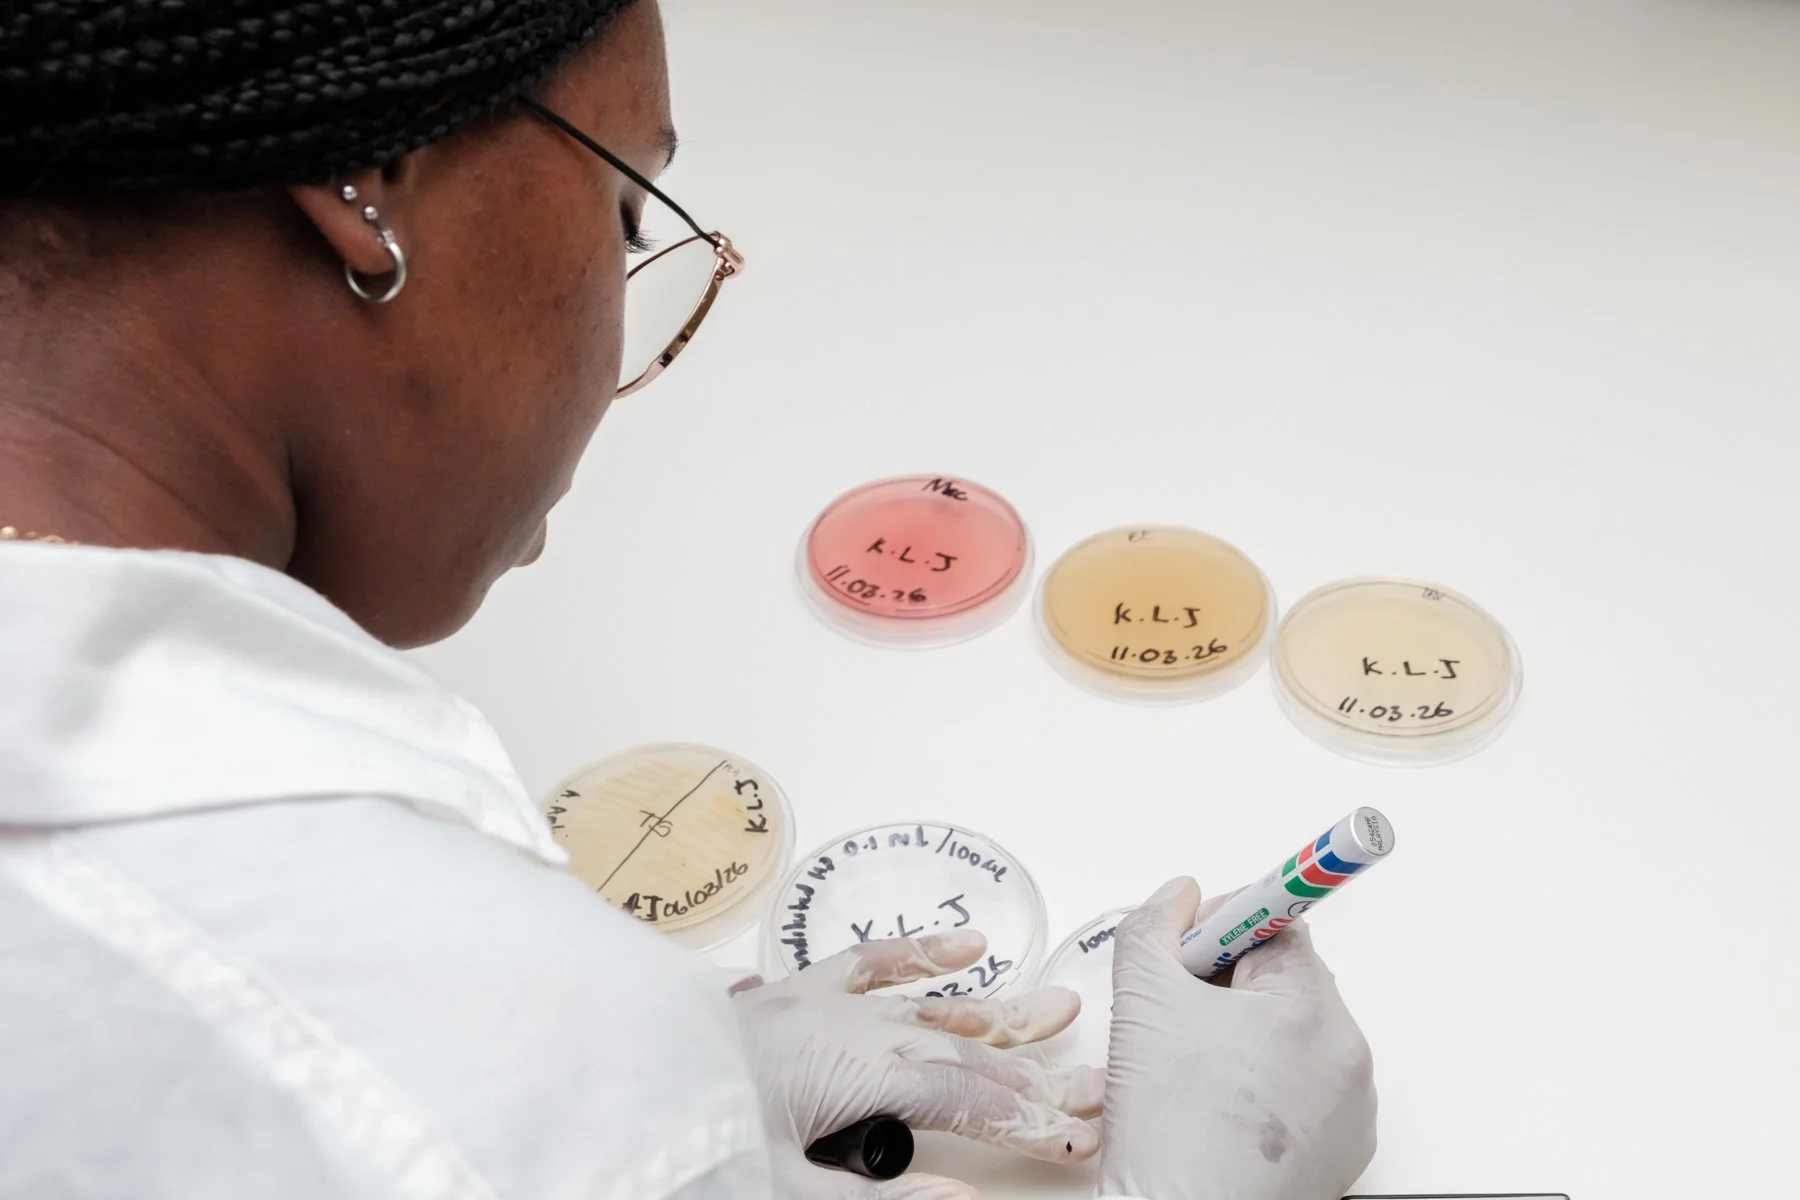
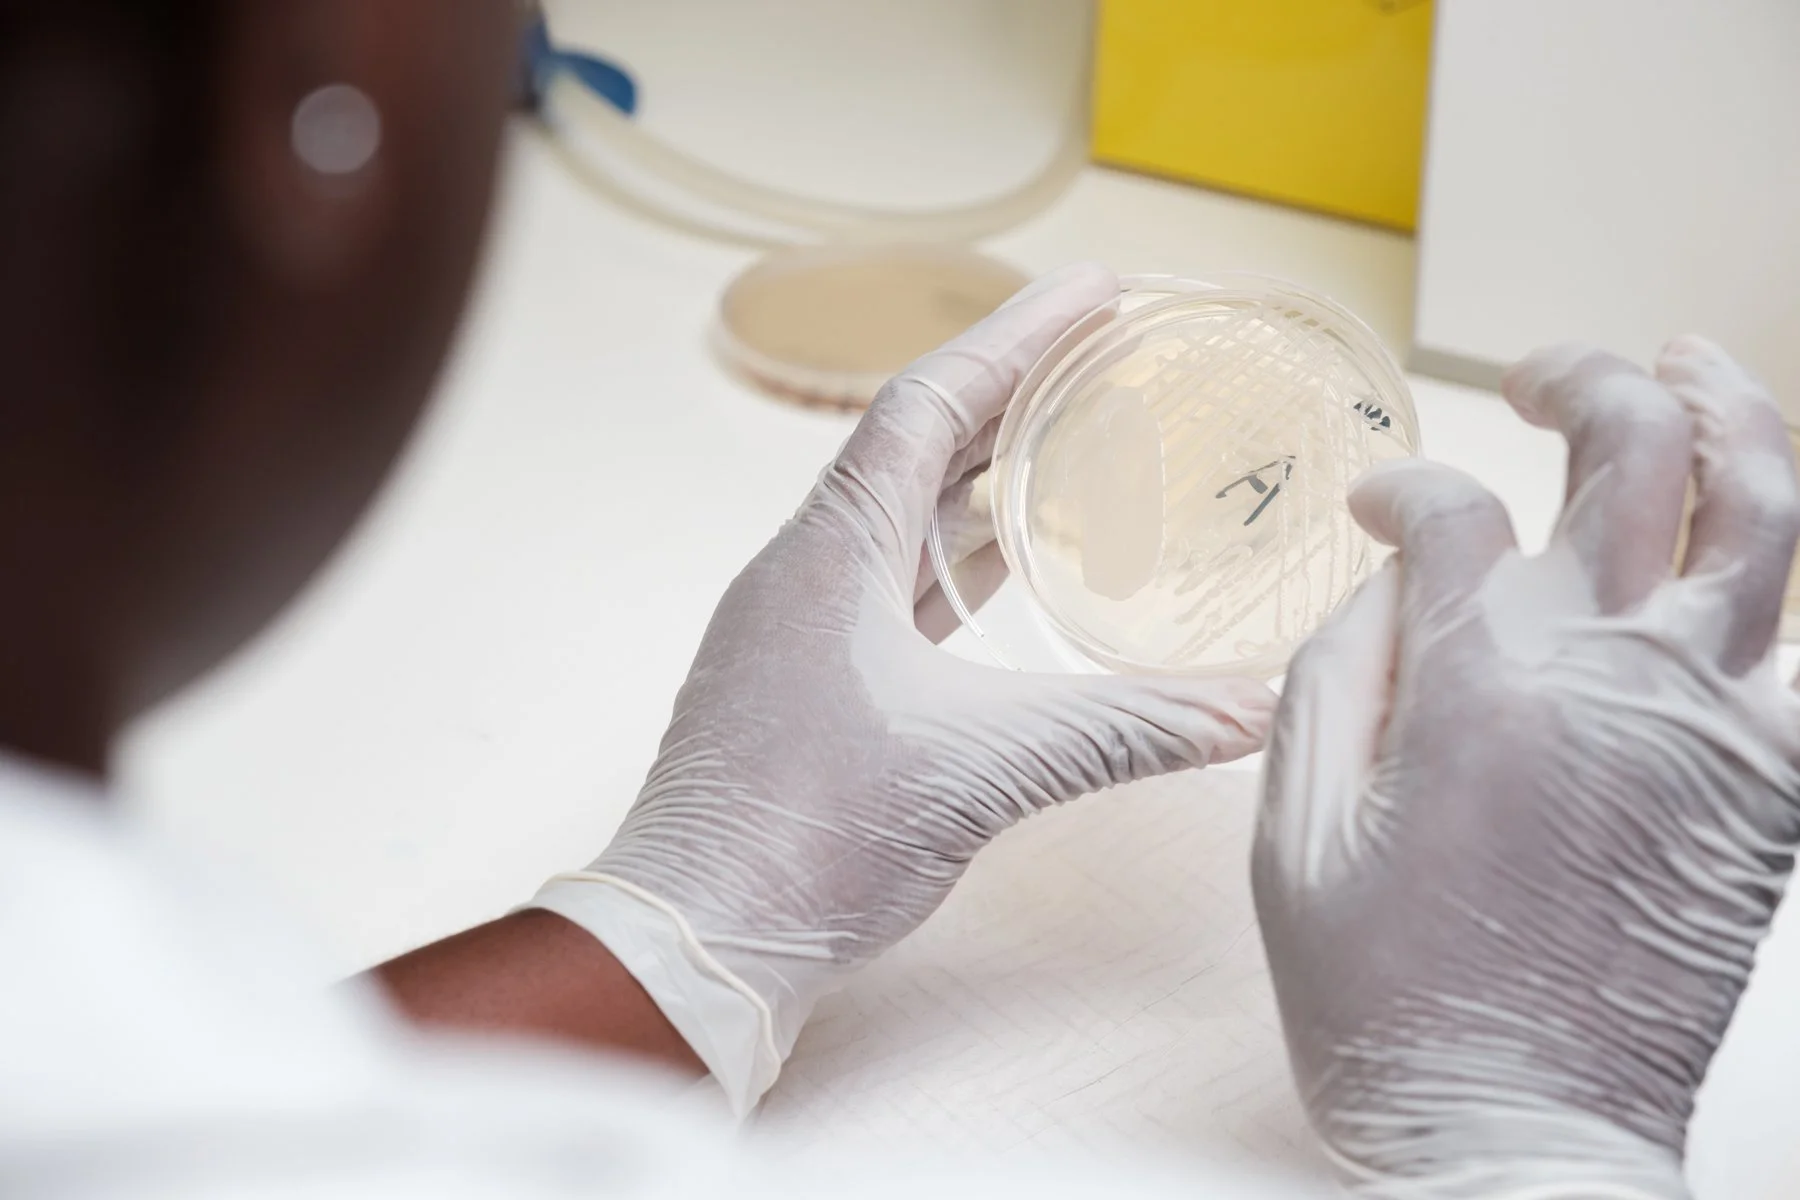

PD Dr Markus Schuppler
Private Lecturer in Microbiology at the Swiss Federal Institute of Technology Zurich
Department of Clinical Health Sciences
Namibia University of Science and Technology
February 27 - March 21, 2026
During my 2026 assignment, I continued teaching third-year students in the Medical Laboratory Sciences Programme within the Department of Clinical Health Sciences, Faculty of Health, Natural Resources and Applied Sciences at NUST. As in previous years, I taught a portion of the Medical Microbiology course with a strong emphasis on Public Health and the molecular pathogenicity of bacterial pathogens relevant to food and drinking water. I delivered this knowledge through lectures, practical sessions, and field trips.
Cooperation with university staff
I have known many staff members involved in the Medical Laboratory Sciences Programme since my first assignment in 2016, or for several years. This long-standing familiarity makes collaboration easy, pleasant, and effective, contributing significantly to the success of my assignment. I am especially grateful to the staff who co-prepare and run the practical courses and organize field trips: Elmarie Eises, Shapopi Kamanja, and Ottilie Udjombala. Their support and expertise have always been invaluable.
I also appreciate the essential background support from other colleagues of the School of Health Sciences such as Vanessa Tjijenda, Charmaine Jansen, and Carolie Cloete. Furthermore, special thanks to Zodidi Gaseb, B360 Coordinator at NUST, and Nico Smit, Country Manager of B360 Namibia, for consistently ensuring a smooth stay at NUST and assisting with day-to-day matters. Their unwavering support greatly enhances the overall experience and success of my assignment.
I am sincerely grateful to all colleagues – directly and indirectly involved in my assignment – for their invaluable contributions.
Since the number of third-year students in the Medical Laboratory Sciences programme is still increasing from year to year, we had 86 participants in our class. Fortunately, the staff is already prepared to manage the high numbers of students. They already developed a practical approach that allowed us to deliver a well-received practical course, also for this high number of students. The students were divided into two groups and each group was assigned to another laboratory. The two laboratories were connected by a corridor that allowed us supervisors to ‘oscillate’ between the two labs.
However, delivering a thorough practical course for such a large number of students proved to be a considerable challenge. While the staff adapted to the high enrolment, the substantial increase still poses significant difficulties. Resources and facilities – such as classrooms, laboratories, staff, and equipment – are not designed to cope with such large numbers of participants, which makes it difficult to accommodate the many students. Considering that I only had to manage this situation for three weeks, I have the utmost respect for the staff’s performance, who work under these circumstances all year.
Next year, third-year enrolments are expected to peak at 140 students. At that scale, the class would need to be divided into four groups, and the practical course would have to be run twice, requiring double the time and space.
Impact and win-win
Being part of the B360 Southbound Program, I am continually grateful for getting the chance to positively influence the education of young people at NUST. I still believe my teaching fills a crucial gap, because the topic might otherwise go uncovered. Consequently, the students would miss the knowledge about key molecular insights into how foodborne pathogens cause disease and the necessary methodology to detect pathogenic bacteria in water and food. By introducing them to the field of food and water microbiology, I have the impression that my contribution helps to shape their understanding and prepares them for their future careers. Furthermore, it also shows them that, in addition to traditional medical laboratories, other fields such as water testing or food analysis may also be viable career options. In conclusion, the feedback that I received from both Medical Laboratory Sciences students and the staff was truly rewarding and motivating. Thus, I believe my teaching tenure at NUST was a mutually beneficial experience and a significant opportunity for all parties involved.
Collaboration with students and memorable events
As always, the students are quite reserved during lectures, making it challenging to encourage active participation through questions or initiating discussions, especially given the current large class sizes. Therefore, I especially value the practical courses and field trips, as they offer excellent opportunities for personal interactions and meaningful discussions with the students. I will never forget their shocked expressions when they see agar plates contaminated with bacteria from their throats or water bottles – moments that illustrate how these hands-on lessons, along with the related theory, linger in memory. Field trips not only break the daily study routine, but also offer insights into future fields of work and job roles, thereby helping students to explore their future career options.
This year, we had the opportunity to visit Gammams Water Care Works Laboratories in Windhoek, an educational and impactful experience. The visit connected the students’ theoretical knowledge from lectures and the practical course with the analyses conducted at Gammams Water Analysis Laboratories, as they perform the same routine diagnostic tests the students recently learned during the drinking water analysis practical. Consequently, this field trip was especially valuable for the Medical Laboratory Sciences students, providing a clear glimpse into an alternative potential future work environment.
Personal message
Recognizing the vital impact of educating young people on Namibia’s economic and social future, I am proud to continue my involvement with B360 education partnerships at the Namibia University of Science and Technology (NUST) in Windhoek.
This program hinges on unwavering commitment and collaboration from all stakeholders, and I am deeply grateful to the teams at B360 and NUST for their tireless work to ensure its success. Together, I hope we can make a small but lasting and meaningful difference in the future well-being of Namibia’s people.